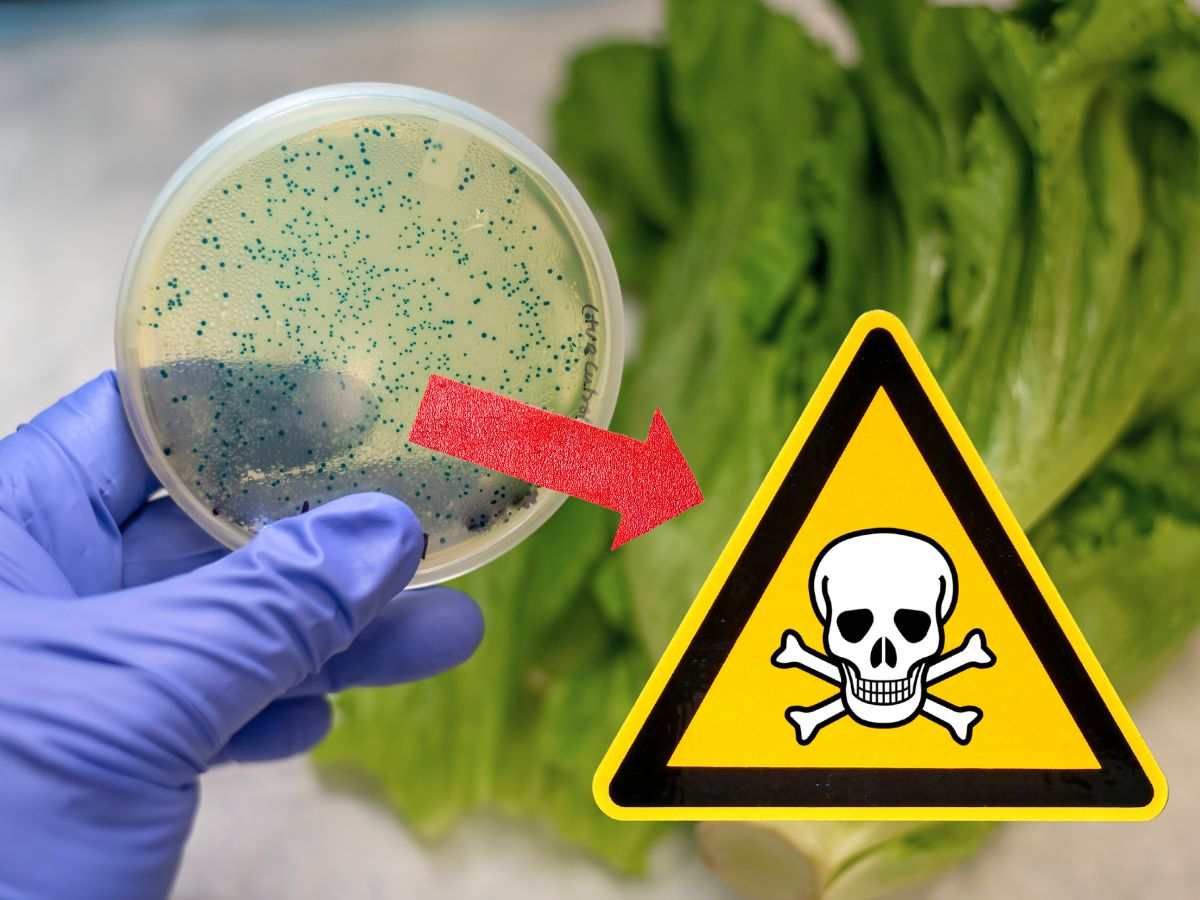

Bisogna assolutamente fare attenzione a questa pianta, perché sembra una lattuga, ma è tra le più tossiche se ingerita!
Questa pianta ha le fattezza di un delizioso cespo di lattuga, in realtà è altamente tossica nelle mani di chi non sa utilizzarla. Si afferma ciò poiché nel passato è stata utilizzata come farmaco, ma solo da chi la conosceva bene. Ecco cos’è successo a chi ne ha fatto un uso improprio, soprattutto quali sono le sue proprietà e cosa farsene se è così letale!
Ci confonde decisamente le idee questa pianta. Sembra una lattuga, ma non lo è. È velenosa, ma in passato è stato utilizzata come farmaco per le sue proprietà, insomma la natura è sempre pronta a stupirci. Non è un caso incontrarla venire attirati dalle sue fattezze, ma occhio, perché non fa bene se ingerita.
L’aspetto più assurdo è che in passato veniva osannata per le sue proprietà magiche, compiendo un gravissimo errore. Era un sedativo e antidolorifico grazie agli alcaloidi come l’atropina, iosciamina e scopolamina che contiene. Dalla pianta si otteneva la tintura usata come rimedio contro le coliche, ulcere gastriche, asma, febbre da fieno e pertosse.
Nei testi di alchimia la radice era considerata una creatura con arti e un volto, il cui urlo avrebbe potuto uccidere un uomo quando la si staccava con le radici dal terreno. Così, veniva estratta mediante rituali.
Ma c’è anche del mito, per il suo aspetto “antropomorfo” le sono state attribuite proprietà magiche come già detto. Pianta preferita delle streghe per gli unguenti, sembra che fosse fondamentale per le pozioni afrodisiache e per combattere la sterilità.
Ecco come fare attenzione a questa pianta, e come si usa
Della famiglia delle Solanaceae assomiglia ad una lattuga, ma anche agli spinaci, allora come distinguerla? È una pianta erbacea perenne senza gambo e le foglie formano una rosetta basale. Queste sono a forma ovato-lanceolata e sono verde scuro, ma c’è un dettaglio che la fa identificare subito… puzzano! Inoltre, i fiori hanno un calice lanceolato e la corolla varia dal verde al giallo. Stessa colorazione per le bacche. Quindi, se la si osserva bene, la si riconosce subito.

Oggi ne è vietato l’uso in erboristeria, ma possiede dei principi attivi che vengono sfruttati in ambito farmaceutico.
Contiene scopolamina che oggi è usata nei farmaci contro nausea e vomito o per coliche biliari e urinarie. La stessa atropina tratta le brachicardie sinusali e medicazioni preanestetiche per ridurre le secrezioni del tratto respiratorio, o ancora in ambito oculistico per fare esami specifici.
Ma è comunque tossica proprio per il contenuto di alcaloidi tropanici che esercitano un’azione antimuscarinica, cioè possono bloccare i recettori dell’acetilcolina, impedendo al neurotrasmettitore di svolgere le sue funzioni comuni nell’organismo. Per questo ci si può avvelenare!
Il nome di questa pianta lo si conosce anche grazie ad un Fantasy per eccellenza: Harry Potter! Ricordate quando a lezione di erbologia hanno estratto una Mandragora? Ecco di che pianta si tratta! Sapevate esistesse davvero e che fosse simile ad una lattuga?





